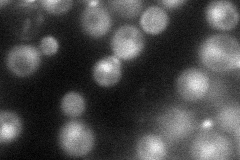
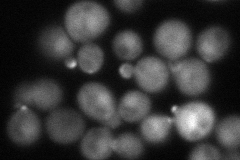
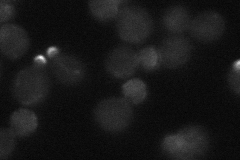

View description
Coiled-coil polarisome protein required for polarized morphogenesis, cell fusion, and low affinity Ca2+ influx; forms polarisome complex with Bni1p, Bud6p, and Spa2p; localizes to sites of polarized growth
Localization:
Intensity:
Fold change:
Significance:
-
C’ GFP library in SD

below threshold17.24 -
N' NOP1pr-GFP in SD
bud75.0142 -
N' TEF2pr-mCherry in SD
bud neck78.0229 -
N' NATIVEpr-GFP in SD
bud neck20.1663 -
N' TEF2pr-VC and Cyto-VN in SD

#N/A0 -
C’ GFP library in SD+DTT

cytosol15.340.88No -
C’ GFP library in SD+H2O2

cytosol16.830.97No -
C’ GFP library in Starvation Media

cytosol14.380.83No -
C’ GFP library on the background of Pup2-DaMP

N/A -
C’ GFP library on the background of CCT mutant

N/A0N/AYes
